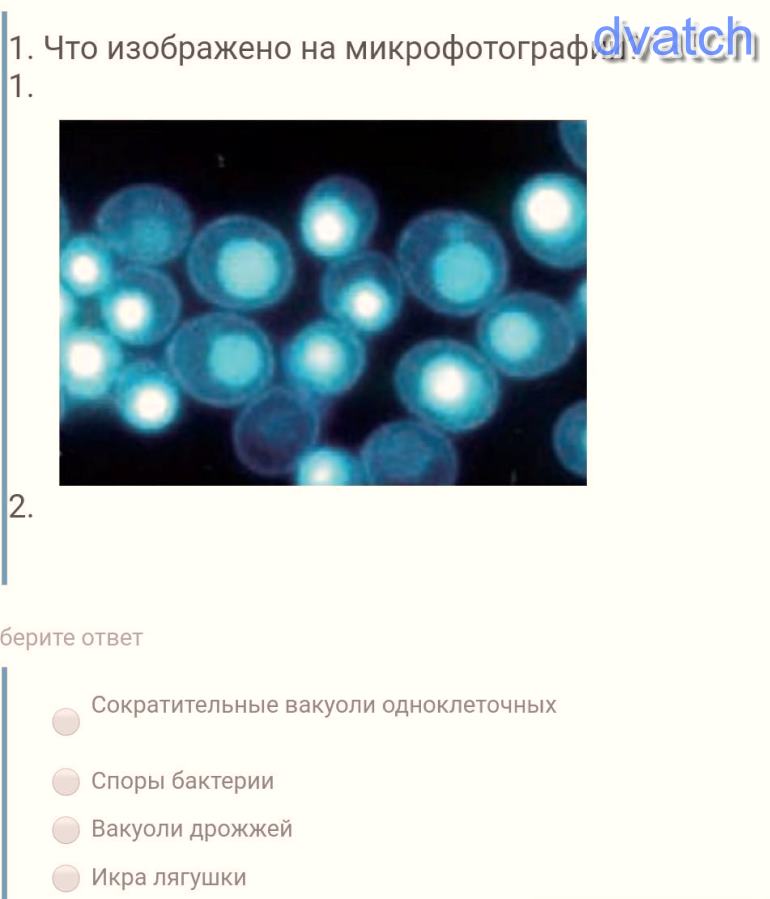

Tygodal
TygodalЧто изображено на микрофотографии?1)Сократительные вакуоли одноклеточных2)Споры бактерии3)Вакуоли дрожжей4)Икра лягушки
ответы: 1
Зарегистрируйтесь, чтобы добавить ответ
Ответ:
одноклетки )
потомучто вакуола спор с . актериями оони вместе а вакуоли дрожжей и икра лягушек не совпадают
346
 Albion
AlbionЧтобы ответить необходимо зарегистрироваться.